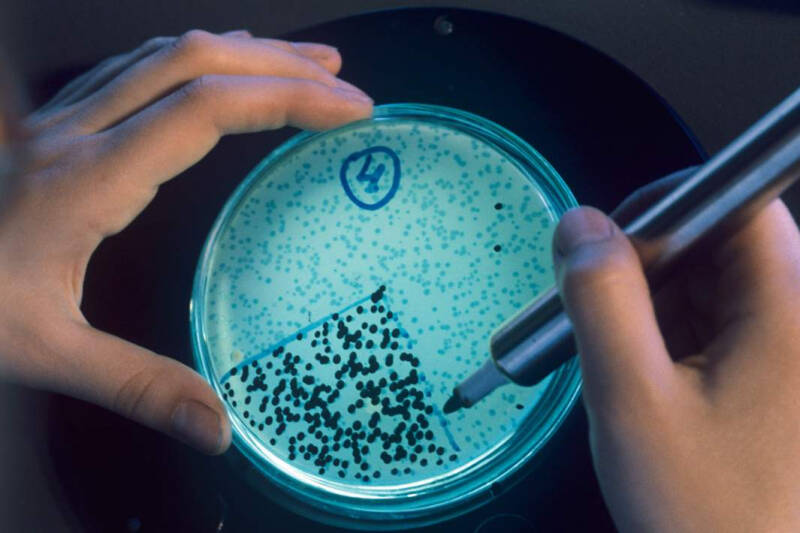
Микроба организм: российские ученые случайно отключили иммунитет бактерий

Микроба организм: российские ученые случайно отключили иммунитет бактерий
Какие перспективы обнаруживает фундаментальное открытие

Российские ученые первыми в мире обнаружили механизм, полностью отключающий иммунитет бактерий. Это происходит при попадании в клетку ДНК определенных паразитарных элементов — плазмид. Открытие было сделано случайно. По мнению экспертов, оно поможет разработать новые методы борьбы с инфекциями и генного редактирования, а также будет полезно для поиска аналогичных «предохранителей» в противовирусной и противомикробной защите человека.
Иммунный стоп-кран
Ученые Сколтеха в ходе исследований обнаружили механизм, который полностью отключает иммунную защиту бактерий. Это происходит, когда в микроорганизм попадают определенные плазмиды — мобильные генетические элементы, которые существуют в клетках как обособленные кольцевые молекулы ДНК. Именно эта ДНК может активировать у микробов встроенную программу подавления иммунитета. Открытие было сделано учеными случайно.

Кампус Сколтеха
— Открытие оказалось для нас совершенно неожиданным. Мы изучали белок, который должен был ингибировать (тормозить. — «Известия») иммунную систему бактерии EcoKI, но данные никак не сходились. Оказалось, что плазмида привлекала нуклеазу (разрушающий ДНК белок. — «Известия») бактерии на свою ДНК. Это запускало программу, которая в норме нужна, чтобы защитить клетку от случайной атаки нуклеазы на собственную хромосому, но оказалось, что плазмидная ДНК настолько активно привлекает на себя этот белок, что это полностью отключает бактериальный иммунитет, — сказал руководитель лаборатории анализа метагеномов Сколтеха Артем Исаев.

Специалисты занимаются изучением взаимодействий между клеточными организмами, к которым относятся бактерии, с мобильными генетическими элементами. Это, например, вирусы — бактериофаги, которые заражают клетки микробов и используют их ресурсы для собственного размножения. Еще один вид мобильных элементов — это плазмиды. Они в чем-то похожи на вирусы, но в отличие от них не способны существовать вне клетки и не приводят к гибели бактерий, а даже иногда могут быть им полезны. Плазмиды легко распространяются от клетки к клетке и иногда встраиваются в их геномы.
Для защиты от вирусов и других мобильных элементов у микроорганизмов существует множество иммунных систем, с помощью которых они разрушают чужеродные ДНК. Однако если такая защита будет слишком эффективной, она может иногда случайно атаковать и собственную ДНК. Похожие аутоимунные заболевания возникают у человека. Чтобы клетка не уничтожала саму себя, ей нужен строгий контроль над иммунитетом.
Один из методов такого контроля — система рестрикции-модификации, которая есть практически у каждой бактерии. Клетка помечает (модифицирует) свою ДНК специальными маркерами. Если их нет, то иммунитет расценивает молекулу ДНК как чужеродную и происходит ее уничтожение (рестрикция). Однако возможны различные осложнения, когда метка со своей ДНК может быть потеряна. Чтобы избежать аутоиммунной реакции, и предусмотрен дополнительный защитный механизм — ослабление рестрикции.

Плазмида, находящаяся внутри клетки, при слишком активном размножении может потерять метку и начать посылать иммунной системе бактерии множество сигналов, что ее нужно атаковать. Однако в результате срабатывания защитного механизма иммунитет бактерии полностью отключается.
Как это происходит у людей
У человека нет системы рестрикции-модификации, поэтому в данном случае сложно провести прямую параллель между нашим и бактериальным иммунитетом. Однако, как полагают ученые, их работа показывает, что защита всегда таит в себе опасность для своего собственного организма. Следовательно, можно ожидать, что и у врожденного иммунитета человека должны быть «предохранители» или «тормоза», похожие на механизм аллевиации рестрикции.
По мнению заведующего лабораторией генного редактирования НИИ молекулярной и клеточной медицины (НИИ МКМ) медицинского института РУДН Эрдэма Дашинимаева, работа сотрудников Сколтеха, кроме фундаментального, имеет и практическое значение.
— Понимание механизмов, регулирующих активность иммунных систем бактерий, может помочь разработать новые методы борьбы с бактериальными инфекциями, совершенствовать технологии доставки генов и редактирования генома, а также откроет перспективы для улучшения стабильности и эффективности плазмид, применяемых в биотехнологиях. Это важно для медицины, сельского хозяйства и промышленности. Кроме того, исследование позволит лучше понять процессы эволюции бактериальных популяций и распространения антибиотикорезистентных генов и штаммов, — сказал Эрдэм Дашинимаев.
С помощью открытого учеными механизма можно подготавливать бактерии к воздействию бактериофагов. В качестве средств борьбы с инфекциями они известны давно, однако их редко применяли, так как бактерии очень быстро вырабатывают к ним иммунитет. Теперь после подобной обработки микробы будут восприимчивы к воздействию любых инструментов, считает научный сотрудник Института иммунологии и физиологии Уральского отделения РАН Михаил Болков.
— Если мы найдем аналог такого защитного механизма у человека, это решит многие проблемы, связанные с аутоиммунными болезнями. Сейчас для этого нам приходится давать пациентам иммунносупрессивные препараты. Открытие также может помочь временно отключать иммунитет при трансплантации, чтобы чужеродные ткани приживались. Однако всё, что связано с отключением иммунитета, часто приводит к осложнениям вплоть до онкологии, поэтому это нужно будет делать деликатно и потребуется множество экспериментов, — сказал он.
Кроме того, в ДНК таких «беззащитных» бактерий можно внедрять нужные команды, чтобы они вырабатывали необходимые гормоны или другие продукты, добавил специалист.



